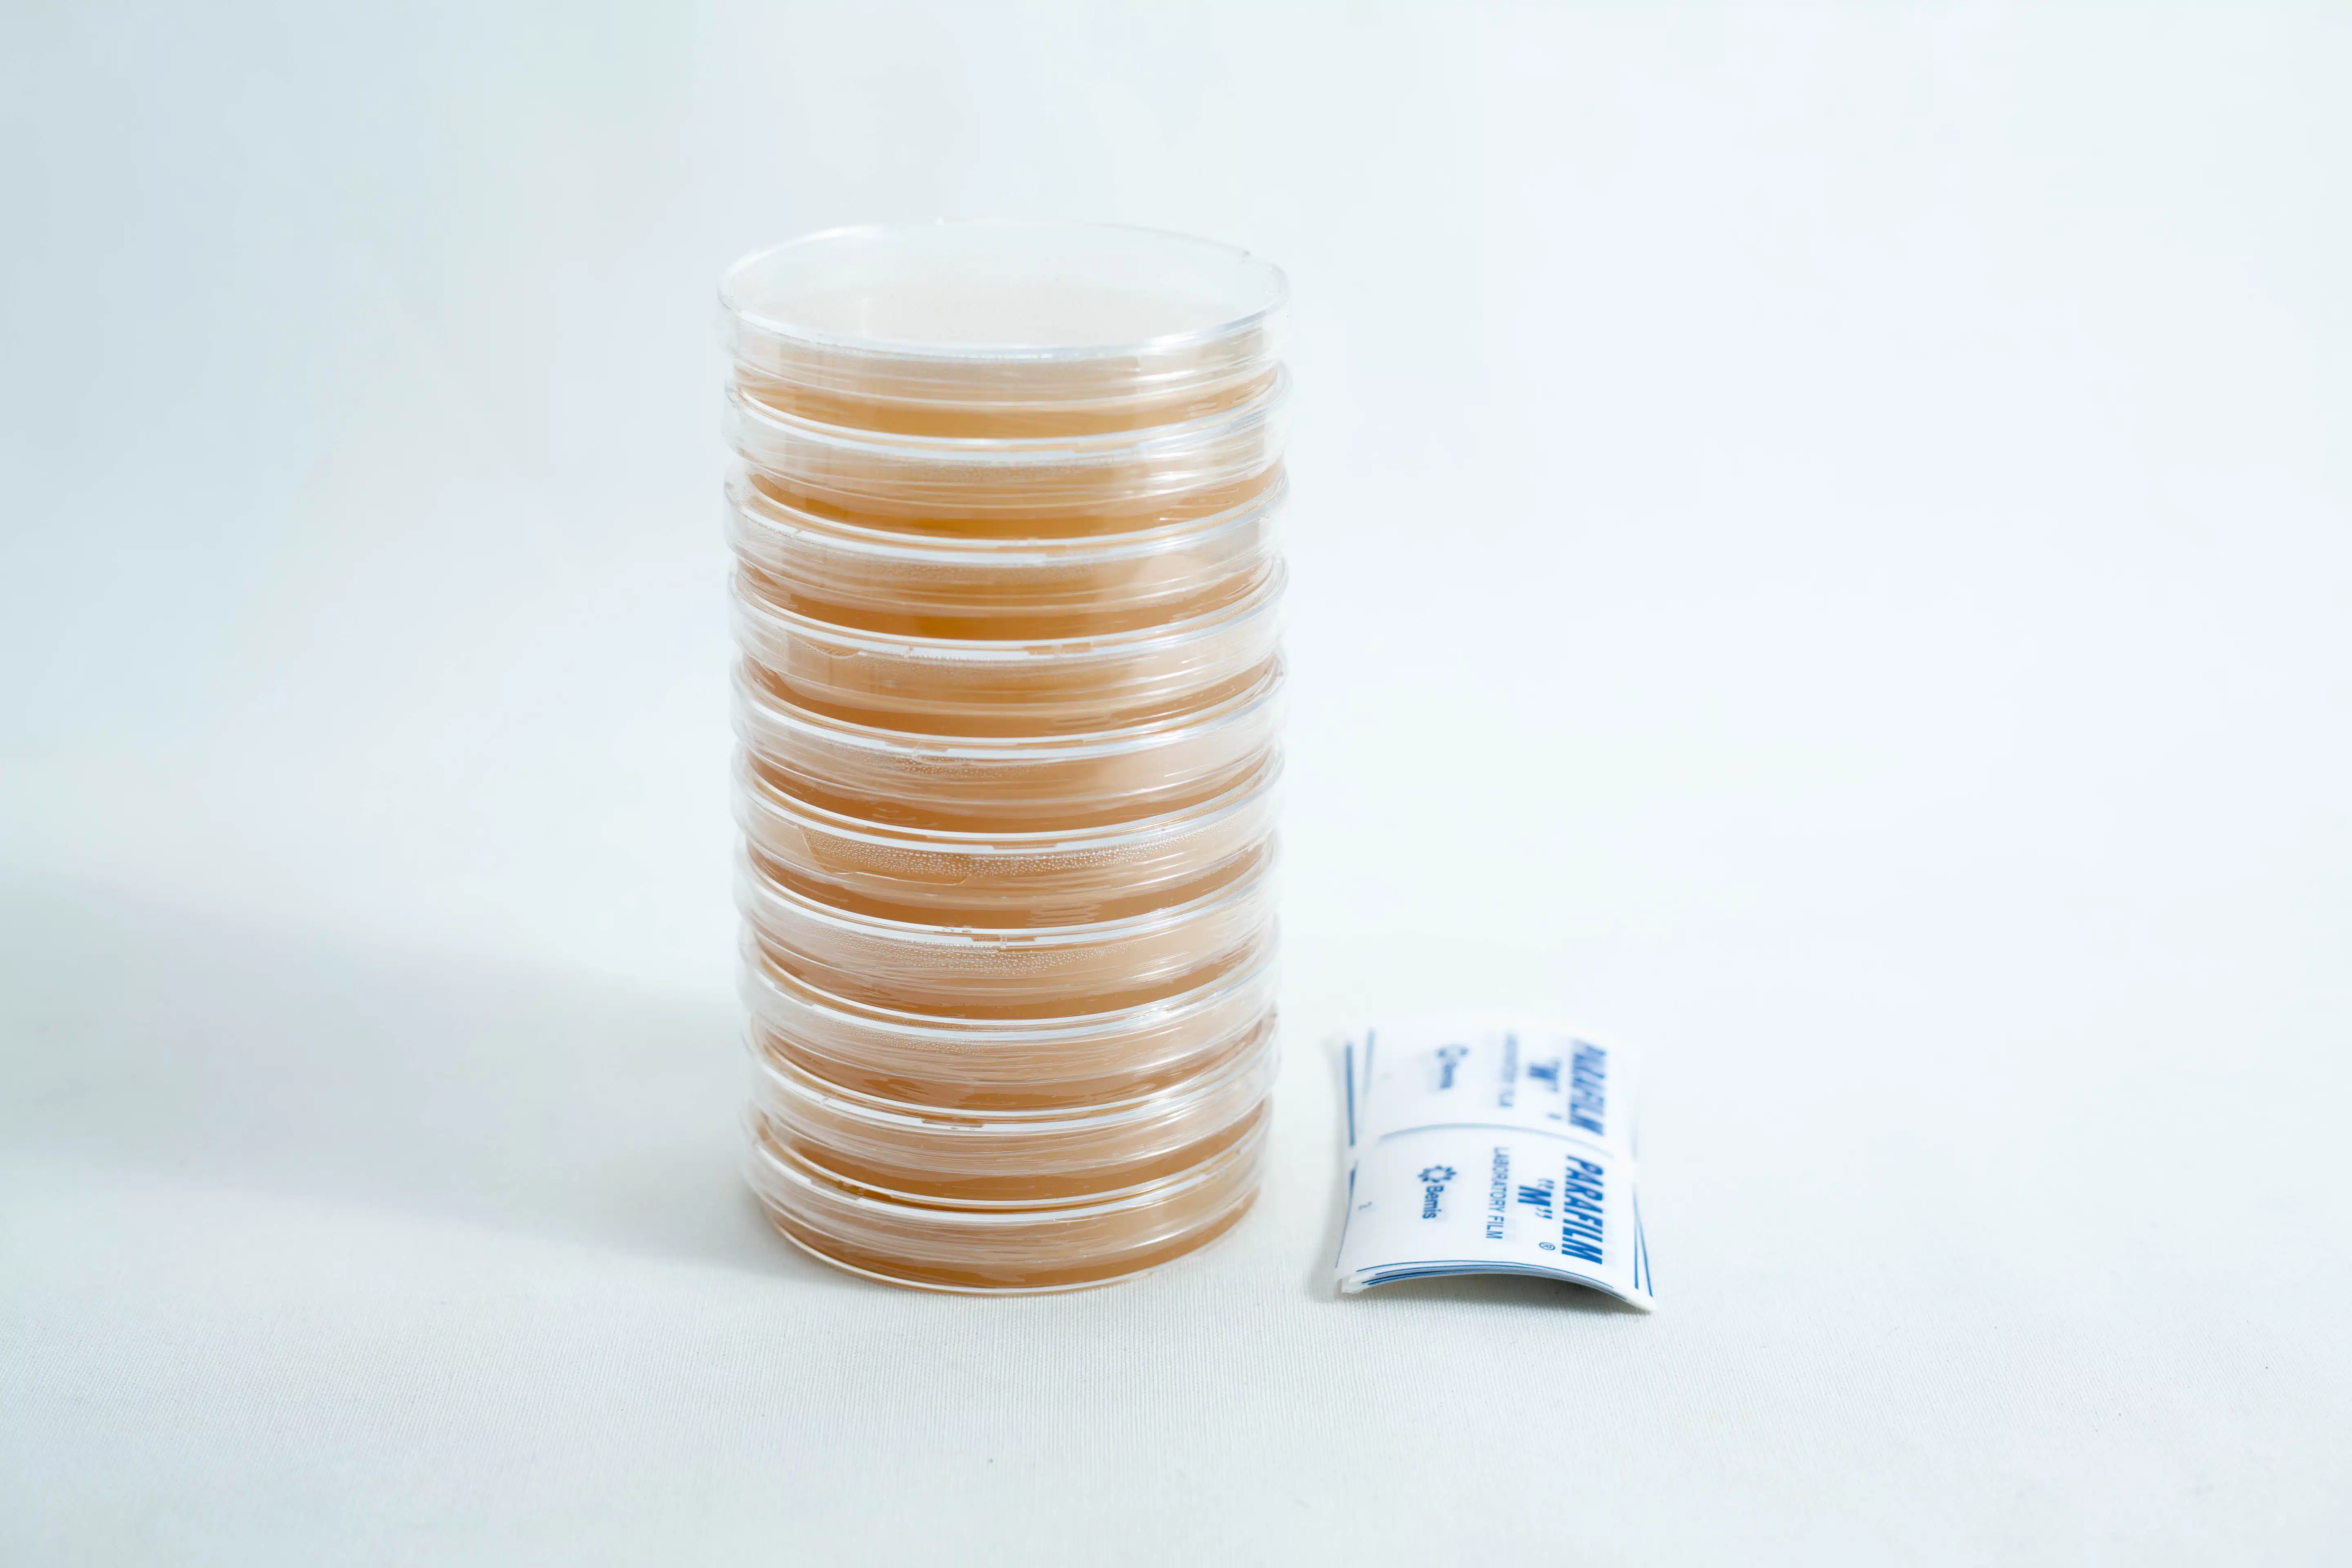
Pre poured MEAG Agar Plates (Antibacterial) 90mm 4 A stack of pre-poured MEAG agar plates (antibacterial) 90mm is placed next to two small packets on a white background.

Description
Please be advised that during the months of December through February, shipping agar plates can be particularly challenging due to environmental factors. When the temperature of the package exceeds 40ยฐC, the plastic wrap or wax parafilm used for sealing may melt, shrink, or otherwise be compromised due to heat. This can increase the likelihood of contamination.
A bubble or condensation on any of the plates is not a cause for concern and does not affect the product’s quality.
If you encounter contamination, please send us a clear photo of the affected plates, along with the number of plates affected and your order number. A refund will be issued upon verification of the issue.
Please note that we are unable to offer replacements, as the same environmental conditions may lead to similar issues. We appreciate your understanding and cooperation during this period.
Pre-poured Petri dishes Malt Extract Agar (MEA) with Anti Bacterial Compounds for mushroom growing.
Your purchase includes
– 10x Parafilm pre-cut strip
– 10x 90mm Petri dish with MEA with Anti Bacterial Compounds comes sealed snugly. These plates are to be stored at room temperature. Do not store them in the fridge unless colonized.
Plate Shelf Life and Storage
The optimal shelf life for plates is 30-45 days. Order plates as needed, as they cannot be stored indefinitely, even in their original packaging. While most plates can last for months, their ideal shelf life is 30 days.
Usage and Contamination
Plates may remain usable beyond 30 days if uncontaminated. If contamination occurs in one plate, it doesn’t affect others in the pack. Discard contaminated plates and use the rest as normal.
The presence of a bubble or condensation in any of the plates is not a cause for concern.
Long-term Storage
Extended storage may cause plates to lose moisture, becoming stiff and papery. Use plates only if they remain gelatinous and uncontaminated. Discard any that become stiff or papery, as they can no longer support organism growth.
Refund Policy
For damaged or contaminated plates upon delivery:
โขโ โ Contact us within 30 days of the ORDER date
โขโ โ Provide photos for refund requests
โขโ โ No replacements are offered; only refunds
Storage Guidelines
Before inoculation:
โขโ โ Store in a cool, dry place (e.g., cupboard)
โขโ โ Avoid refrigeration to prevent condensation
โขโ โ Place upside down to minimize condensation
After colonization:
โขโ โ Refrigerate when at least 60% colonized
โขโ โ Label (date and species) and put in zip-lock bags for storage
โขโ โ It is best to keep it in the vegetable compartment of the fridge
Remember: The packaging sleeve is not a sterile seal. Proper storage is crucial for maintaining plate quality.
About the petri dish
These dishes are made of clear polystyrene, which allows for clarity while being disposable and durable. It is easy to stock and grip and has an anti-slip ring that offers stability.
General MEAG information
MEAG is a gelatinous medium that is used to purify, germinate, isolate, and manipulate mushroom mycelium to reduce the chances of contamination drastically due to its antibacterial compound.
These Petri dishes are 100% ready to inoculate with spores or mushroom mycelium. Its key feature is anti-bacterial compounds. In Agar mycelium cultures, antibacterial compounds have been demonstrated to inhibit bacteria to a confinable level. In several cases, spores are infected with bacteria attached to them, and they carry it to the Agar media. This will germinate fast-growing bacterial spores that make it difficult for mushroom spores to germinate (as they are slower compared to bacterial spores).
On the other hand, when infected spores are introduced to MEAG, the mushroom spores will germinate and grow, leaving behind bacterial contamination. That is because the cells composing the mycelium (Hyphae) have long and sharp filaments, which carry reduced populations (if any) when they pass through the Anti Bacterial Compounds as they grow. These plates will not prevent the growth of other contaminants that are not bacteria.
We recommend MEA with Anti Bacterial Compounds for
- ย Germinating spores from a spore syringe or spore print has a likelihood of contamination.
- ย Isolating a specific strain of mushroom
- ย Wild mushroom cloning
- ย Purify mycelium from other contaminated agar plates or liquid culture
Malt Extract
Malt extract contains a high concentration of maltose, which provides a suitable environment for the growth of fungi. That is due to its rich source of carbon, protein, and nitrogenous compounds used as energy for fungi growth.
Agar-Agar
Agar-Agar is extracted from various seaweeds, such as gracilaria and gelidium (It contains no animal ingredients. Due to Agar’s unique gel property and stability, it is used as a firming and thickening agent for Petri dish experimentation.)In an unlikely situation when you receive some plates damaged or contaminated that may arise sometime from shipping, we will refund you part payment for those affected plates. Please send us the photos within one week of receiving the parcel.
We offer other Pre-Poured Agar plates in our store.
You can also buy theย Anti-Bacterial powderย from our store or otherย pre-made Agar mixesย to make your own agar plates.